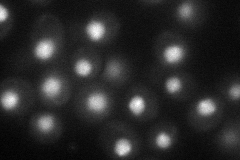
YLR453C
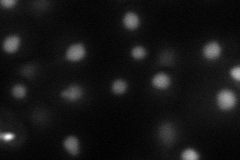
YLR453C
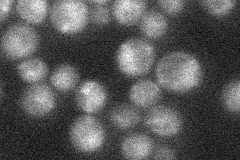
YLR453C
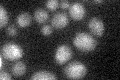
YLR453C

View description
Protein that binds to the Rap1p C-terminus and acts synergistically with Rif1p to help control telomere length and establish telomeric silencing; deletion results in telomere elongation
Localization:
Intensity:
Fold change:
Significance:
-
C’ GFP library in SD

nucleus:cytosol19.66 -
N' NOP1pr-GFP in SD
punctate,nucleus46.7231 -
N' TEF2pr-mCherry in SD
nucleus34.6412 -
N' NATIVEpr-GFP in SD
ambiguous23.5168 -
N' TEF2pr-VC and Cyto-VN in SD

nucleus30.3903 -
C’ GFP library in SD+DTT

nucleus.cytosol19.360.98No -
C’ GFP library in SD+H2O2

nucleus.cytosol19.691No -
C’ GFP library in Starvation Media
nucleus,cytosol26.221.33No -
C’ GFP library on the background of Pup2-DaMP

nucleus:cytosol -
C’ GFP library on the background of CCT mutant

nucleus:cytosol18.00140.915239No
